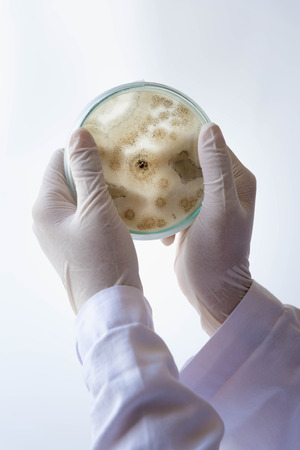
equipment and science experiments ; science backgroundの写真素材

写真素材 - equipment and science experiments ; science background
キーワード
- analysis
- aspergillus
- background
- biology
- biotech
- biotechnology
- bottle
- chemical
- chemicals
- chemistry
- color
- colorful
- development
- discovery
- equipment
- experiment
- flask
- flasks
- glass
- glassware
- graduated
- group
- industry
- instrument
- lab
- laboratory
- liquid
- medical
- medication
- medicine
- microbiology
- niger
- pharmaceutical
- pharmacology
- pharmacy
- physical
- research
- sample
- science
- scientific
- solution
- table
- technology
- test
- toxic
- transparent
- tube
- tubes
- water
- white
類似作品
Group of labora...
Beaker and test...
Group of labora...
chemical soluti...
Researchers wor...
a study of medi...
Top view of lab...
Table with a mi...
Pharmacy and ch...
Medical science...
Glass bowl with...
Concept of scie...
BEIJING, CHINA ...
Pharmacy and ch...
Group of labora...
Doctor in the l...
Close up covid-...
Vertical format...
Biological rese...
Labaratory glas...
Medical science...
Biological rese...
Different labor...
Microscope and ...
Close up of sci...
Chemical tubes ...
Laboratory Rese...
Close up of lab...
Test tubes flas...
Concept of scie...
lab glassware m...
Pharmacy and ch...
Measurement of ...
Pharmacy and ch...
Test tubes flas...
Chemical reagen...
lab glassware m...
Pharmacy and ch...
Photo Different...
school laborato...
Equipment and s...
Laboratory inte...
test tubes with...
Scientific back...
stand with tube...
Chemical labora...
laboratory equi...
Test tubes on a...